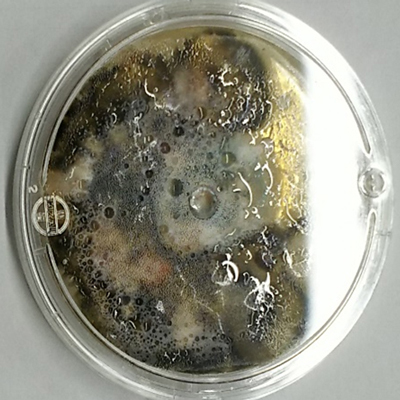
カビこんばい

Business 事業内容
- 事業内容
- クリーンルーム
- クリーンブース
- KAMATAアルミフレーム
- 協働ロボット設計製作・自動化支援
- 熱中症対策局所ブース
- 気密検査カプラー
- マルチカプラー
- 現地工事
- 機械 設計製作・改造
- とおさないフィルター
- 窓換気ネット
- 漏えい対策
- 伝動・搬送ベルト
- 緊急用シャワーブース EシャワーⅡ
- 緊急用シャワーブース EシャワーⅢ
- 圧力分布測定システム
- ベルトメンテナンス
- 静電気対策品
- 表面処理
- 蒸気管理システム・機器
- > more
食品工場でも安心、持続する抗菌・防カビ剤「カビこんばい」

1、食品工場や調理場でのご使用も可能
2、お子様やペットのいる所でも安心な成分
3、建物内外あらゆる場所に塗布可能
4、600種以上の細菌・カビ・藻類を防菌
5、長期に安定して効果を持続
6、耐性菌を作らない抗菌・防カビ機能
使用方法
1、底に成分が残らないように良く振ってから使用して下さい。スプレー・刷毛・ローラー・布に含ませる等で塗布して下さい。
2、本剤を定着させ抗菌・防カビ効果を長期に持続させるため、対象面が乾燥している状態で塗布し、再び乾燥させて下さい。
3、対象物にカビの生えている場合は、除菌・清掃後良く乾燥させてから塗布して下さい。
比較試験
ユーザー様のラインで菌を採取させていただき、下記の通り比較試験を実施
| カビこんばい塗布 | アルコール塗布 | 塗布なし | |
| 1日目 |  |  |  |
| 2日目 |  | |  |
※上記テストは効果を比較するもので、効果を保証するものではありません
食品用ベルトカビ培養試験
食品用ベルトにカビこんばいを塗付しカビ抵抗試験を実施しました。
◎ 試験方法:62菌を試験菌としたカビ抵抗性試験
◎ 接種:湿式法による試験菌混合胞子懸濁液直接接種
◎ 培地:クロラムフェニコール等の抗生物質無添加、ポテトデキストローズアガー(PDA)
◎ シャーレ:角型シャーレ
◎ 培養器と培養条件:
培養器 :温度、湿度サーモスタット付きサーキュレーター
培養条件:温度;30℃±5℃ 変換時24℃~35℃
湿度;95%±5%RH 変換時90%RH以上
風速;60cm/sec
◎ サーキュレーター内の確認:培地に木綿の紐を浸しサーキュレーター内に吊るし、
試料と同一条件の接種を行いサーキュレーター内が菌の発育に適していることを確認
◎ 培養期間:28日間
28日後試験結果
| 食品ベルト1 カビこんばい塗布 | 食品ベルト2 カビこんばい塗布 | 食品ベルト カビこんばい塗布なし |
 |  |  |
※塗布した時に水分をはじいてしまう為、食品ベルト1は下地処理をした後塗布
結果判断 ※促進試験を行っておりますので、カッコ内の期間が実際の期間の目安です。
| 培養期間 | ||||
| 7日目 (半年) | 14日 (1年) | 21日 (2年) | 28日目 (3~5年) | |
| 食品ベルト1 カビこんばい塗布 | 0 | 0 | 0 | 0 |
| 食品ベルト2 カビこんばい塗布 | 0 | 0 | 1~2 | 2~3 |
| 食品ベルト3 カビこんばい塗布なし | 0~1 | 1~2 | 3~4 | 4 |
0:カビの発育が全く見られない。
1:僅かに発育が見られる。
2:少し発育が見られる。
3:中間的な発育が確認できる。
4:激しい発育が見られる。
※上記試験は効果を確認するもので保証するものではありません。
とおさないフィルターの紹介ページ
「カビこんばい」によって、とおさないフィルターのカビの発生を防ぐことができます。
とおさないフィルターは、エアコン吹き出し口に設置し、虫の侵入を防げる製品です。











